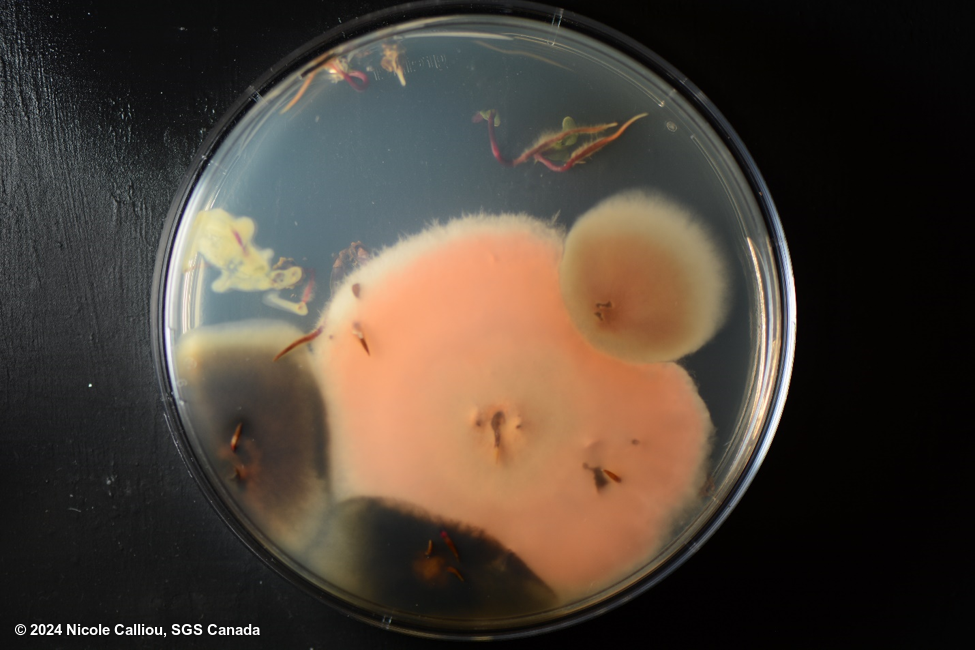

Pathogen
Fusarium equiseti
Overview
|
Scientific name
|
Fusarium equiseti |
|
Genus
|
Fusarium |
|
EPPO code
|
GIBBIN |
|
Common name
|
Head blight, root rot |
|
Synonyms
|
Gibberella intricans |
Description
From ISTA Common Laboratory Seed Health Testing Methods for Detecting Fungi:
On blotters: Presence of small to big, orange coloured pionnotes on seed is characteristic of the species. Usually, the number of pionnotes is high, occupying a large area of the infected seed. The pionnotes can be wet, dry looking like rocks, or sometimes accompanied by scanty mycelium.
Conidia are hyaline, falcate with a well developed pedicellate foot cell and an attenuated apical cell which is highly bent inwards, 3-7 septate but generally 5 septate, the lowermost and uppermost septa are slightly darkery than others, 22-60 x 3.5-6μm.